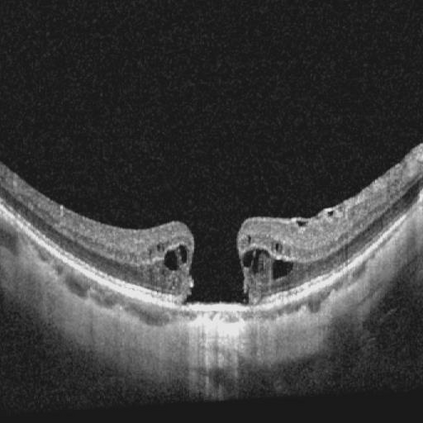
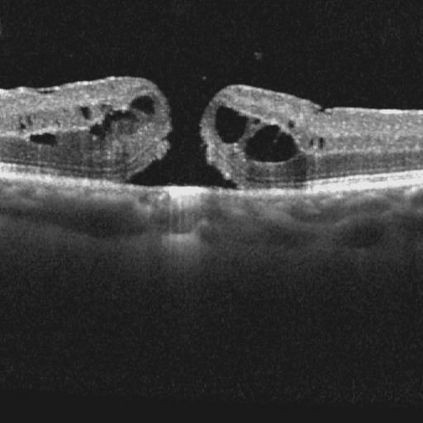

Ophthalmology relies heavily on detailed image analysis for diagnosis and treatment planning. While large vision-language models (LVLMs) have shown promise in understanding complex visual information, their performance on ophthalmology images remains underexplored. We introduce LMOD, a dataset and benchmark for evaluating LVLMs on ophthalmology images, covering anatomical understanding, diagnostic analysis, and demographic extraction. LMODincludes 21,993 images spanning optical coherence tomography, scanning laser ophthalmoscopy, eye photos, surgical scenes, and color fundus photographs. We benchmark 13 state-of-the-art LVLMs and find that they are far from perfect for comprehending ophthalmology images. Models struggle with diagnostic analysis and demographic extraction, reveal weaknesses in spatial reasoning, diagnostic analysis, handling out-of-domain queries, and safeguards for handling biomarkers of ophthalmology images.
翻译:暂无翻译